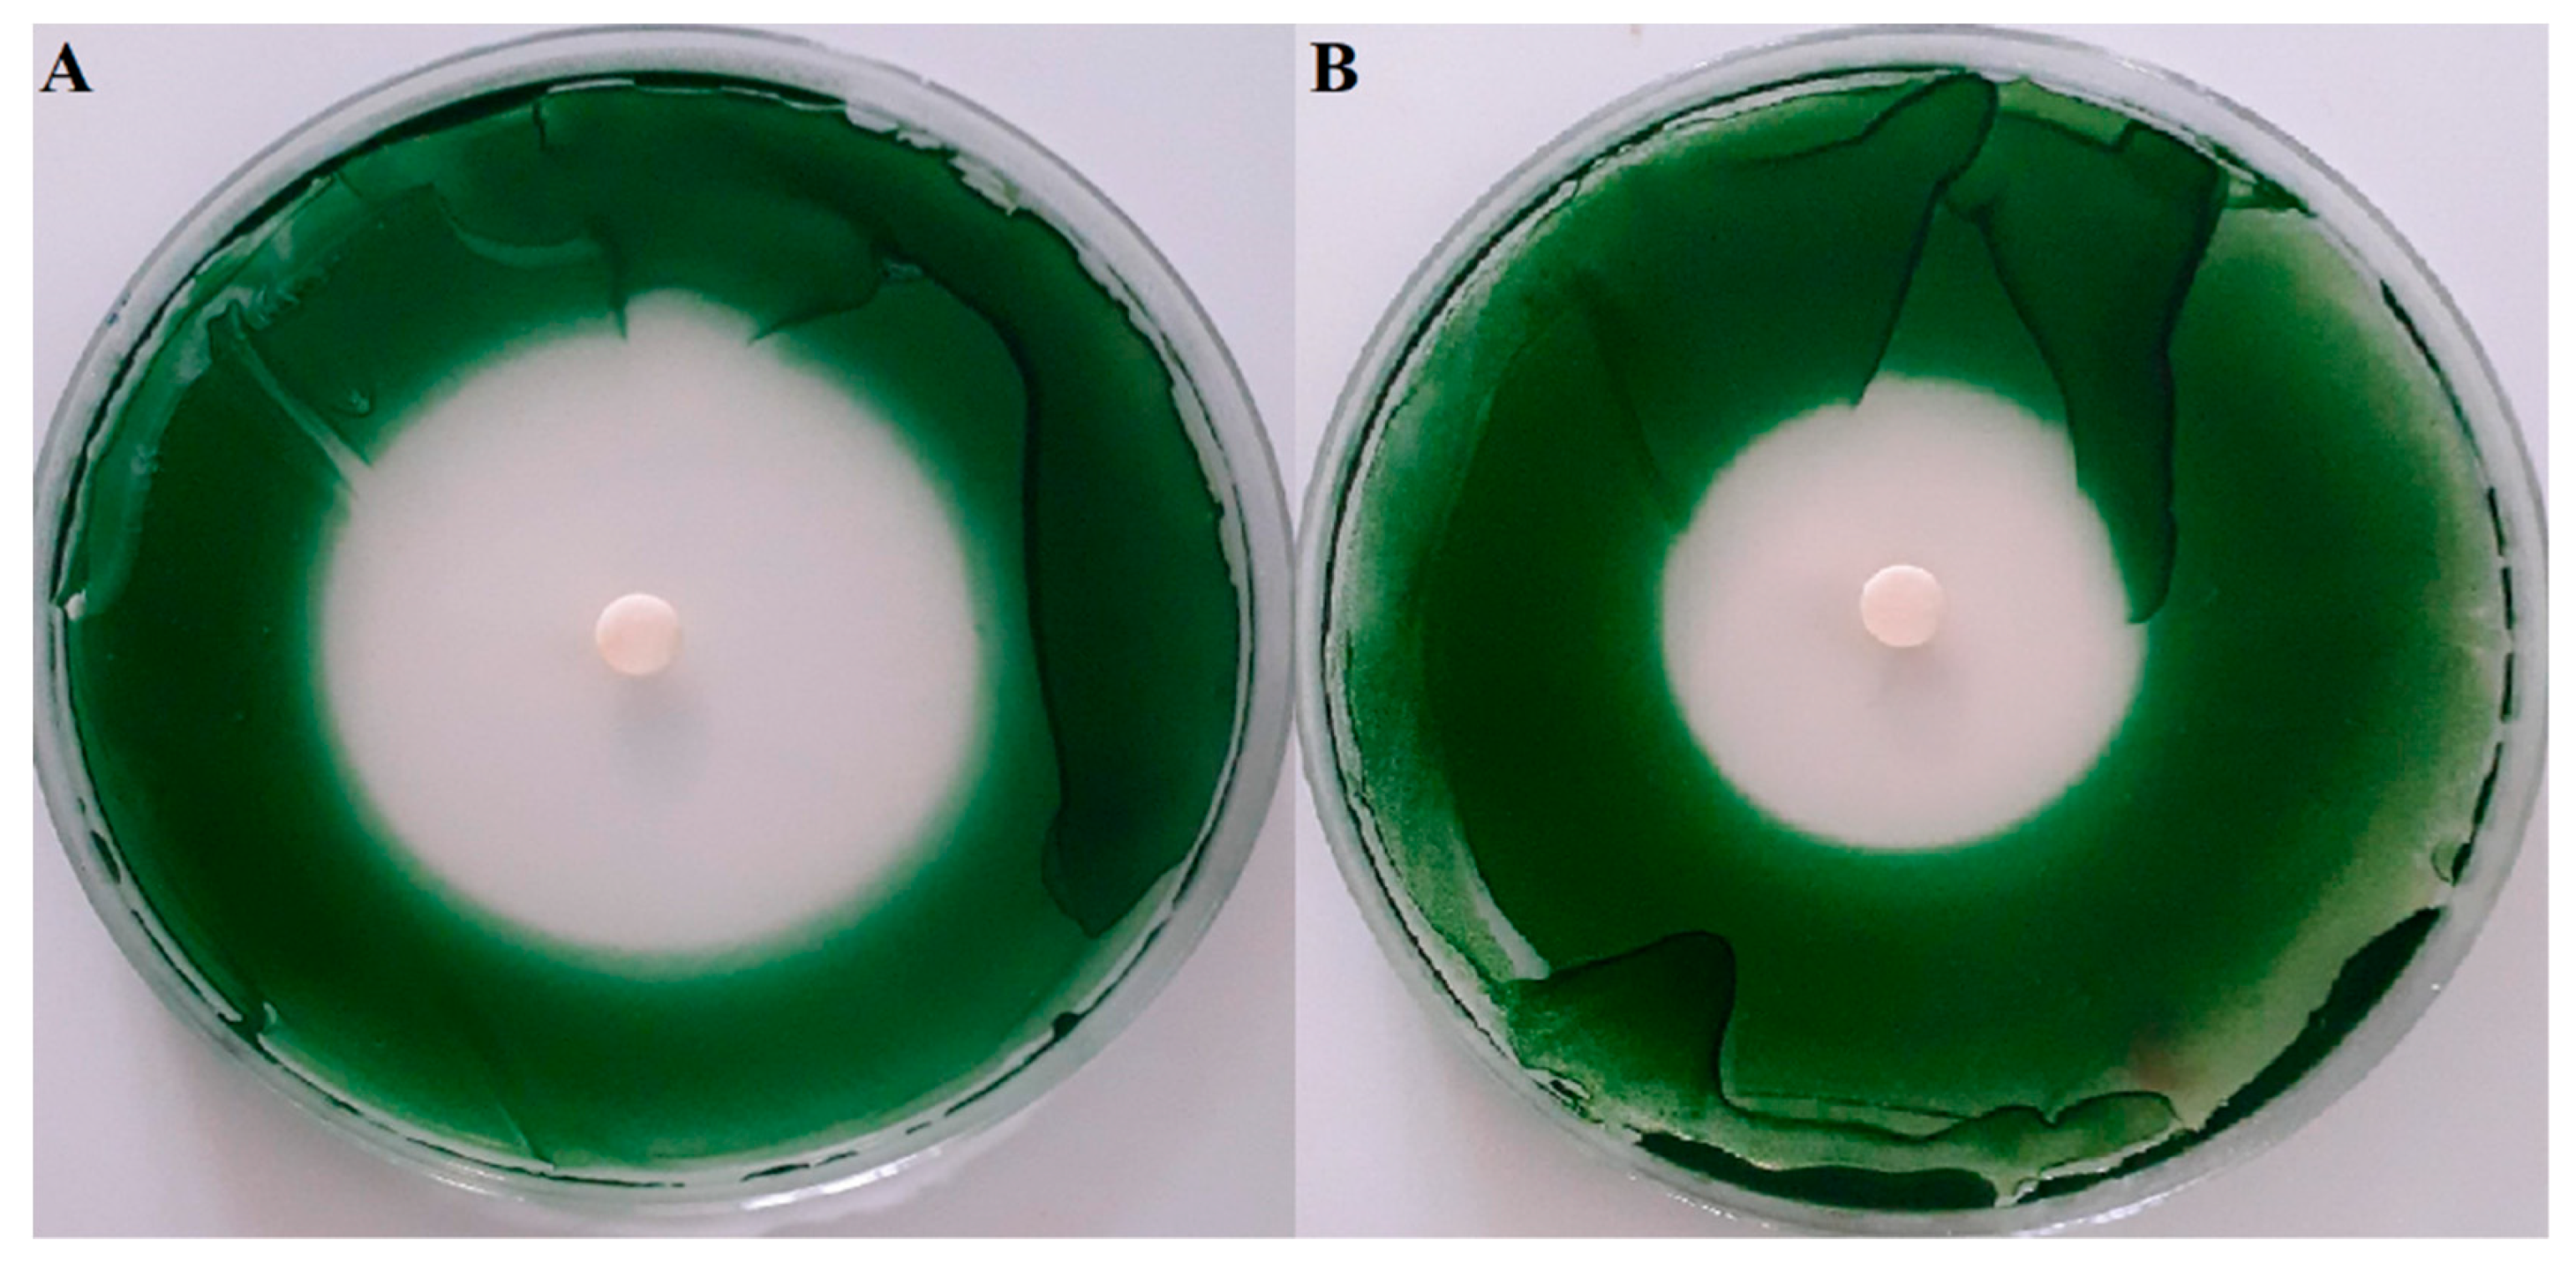

Seaweed Essential Oils as a New Source of Bioactive Compounds for Cyanobacteria Growth Control: Innovative Ecological Biocontrol Approach
Abstract
1. Introduction
2. Results
2.1. Chemical Composition of Moroccan Seaweed EOs
2.2. Screening of Anti-Cyanobacterial Activity
2.3. Physiological Effects of C. tamariscifolia EO on M. aeruginosa
2.3.1. Inhibitory and Growth Rates of C. tamariscifolia EO on Tested Cyanobacteria
2.3.2. Morphological Changes of M. aeruginosa Cells
2.3.3. Effects of C. tamariscifolia EO on M. aeruginosa Chlorophyll-a and Protein Contents
2.3.4. Effects of C. tamariscifolia EO Superoxide Dismutase (SOD) and Catalase (CAT) Activities and Malondialdehyde (MDA) Concentration in M. aeruginosa Cells
3. Discussion
4. Conclusions
5. Materials and Methods
5.1. Seaweed Material Sampling and Extraction of Essential Oils (EOs)
5.2. Gas Chromatography/Mass Spectrometry (GC/MS) Analyses
5.3. Screening for Anti-Cyanobacterial Activity
5.3.1. Cyanobacteria Strain
5.3.2. Disc Diffusion Method
5.3.3. Determination of the Minimum Inhibitory Concentration (MIC) and Minimum Bactericidal Concentration (MBC)
5.4. Determination of Cyanobacteria Growth Rates
5.5. Biochemical Parameters in M. aeruginosa
5.5.1. Determination of Chlorophyll-a and Total Protein Contents
5.5.2. Activity of Antioxidant Response Enzymes, CAT and SOD
5.5.3. Determination of MDA Content
5.6. Statistical Analysis
Author Contributions
Funding
Conflicts of Interest
References
- Chapra, S.C.; Boehlert, B.; Fant, C.; Bierman, V.J.; Henderson, J.; Mills, D.; Mas, D.M.L.; Rennels, L.; Jantarasami, L.; Martinich, J.; et al. Climate change impacts on harmful algal blooms in u.s. freshwaters: A screening-level assessment. Environ. Sci. Technol. 2017, 51, 8933–8943. [Google Scholar] [CrossRef] [PubMed]
- O’Neil, J.M.; Davis, T.W.; Burford, M.A.; Gobler, C.J. The rise of harmful cyanobacteria blooms: The potential roles of eutrophication and climate change. Harmful Algae 2012, 14, 313–334. [Google Scholar] [CrossRef]
- Rigosi, A.; Carey, C.C.; Ibelings, B.W.; Brookes, J.D. The interaction between climate warming and eutrophication to promote cyanobacteria is dependent on trophic state and varies among taxa. Limnol. Oceanogr. 2014, 59, 99–144. [Google Scholar] [CrossRef]
- Redouane, E.M.; Zerrifi, S.E.A.; El Khalloufi, F.; Oufdou, K.; Oudra, B.; Lahrouni, M.; Campos, A.; Vasconcelos, V. Mode of action and faith of microcystins in the complex soil-plant ecosystems. Chemosphere 2019. [Google Scholar] [CrossRef]
- Mohamed, Z.A.; Hashem, M.; Alamri, S.A. Growth inhibition of the cyanobacterium Microcystis aeruginosa and degradation of its microcystin toxins by the fungus Trichoderma citrinoviride. Toxicon 2014, 86, 51–58. [Google Scholar] [CrossRef]
- Sun, Y.; Wang, H.; Guo, G.; Pu, Y.; Yan, B.; Wang, C. Isolation, purification, and identification of antialgal substances in green alga Ulva prolifera for antialgal activity against the common harmful red tide microalgae. Environ. Sci. Pollut. Res. 2016, 23, 1449–1459. [Google Scholar] [CrossRef]
- Zerrifi, S.E.A.; El Khalloufi, F.; Oudra, B.; Vasconcelos, V. Seaweed bioactive compounds against pathogens and microalgae: Potential uses on pharmacology and harmful algae bloom control. Mar. Drugs 2018, 16, 55. [Google Scholar] [CrossRef] [PubMed]
- Marzbali, M.H.; Mir, A.A.; Pazoki, M.; Pourjamshidian, R.; Tabeshnia, M. Removal of direct yellow 12 from aqueous solution by adsorption onto spirulina algae as a high-efficiency adsorbent. J. Environ. Chem. Eng. 2017, 5, 1946–1956. [Google Scholar] [CrossRef]
- Park, J.; Church, J.; Son, Y.; Kim, K.; Lee Hyoung, W. Recent advances in ultrasonic treatment: Challenges and field applications for controlling harmful algal blooms (HABs). Ultrason. Sonochem. 2017, 38, 326–334. [Google Scholar] [CrossRef] [PubMed]
- Pathak, J.; Singh, P.R.; Häder, D.P.; Sinha, R.P. UV-induced DNA damage and repair: A cyanobacterial perspective. Plant Gene 2019, 19, 100194. [Google Scholar] [CrossRef]
- Visser, P.M.; Ibelings, B.W.; Bormans, M.; Huisman, J. Artificial mixing to control cyanobacterial blooms: A review. Aquat. Ecol. 2016, 50, 423–441. [Google Scholar] [CrossRef]
- Huh, J.; Ahn, J.-W. A Perspective of chemical treatment for cyanobacteria control toward sustainable freshwater development. Environ. Eng. Res. 2017, 22, 1–11. [Google Scholar] [CrossRef]
- Nagai, T.; Aya, K.; Yoda, I. Environmental toxicology comparative toxicity of 20 herbicides to 5 periphytic algae and the relationship with mode of action. Environ. Toxicol. 2016, 35, 368–375. [Google Scholar] [CrossRef] [PubMed]
- Pohl, J.; Saltsman, I.; Mahammed, A.; Gross, Z.; Roder, B. Inhibition of green algae growth by corrole-based photosensitizers. J. Appl. Microbiol. 2015, 118, 305–312. [Google Scholar] [CrossRef]
- Coloma, S.E.; Dienstbier, A.; Bamford, D.H.; Sivonen, K.; Roine, E.; Hiltunen, T. Newly isolated Nodularia phage influences cyanobacterial community dynamics. Environ. Microbiol. 2017, 17, 273–286. [Google Scholar] [CrossRef]
- Gerphagnon, M.; Macarthur, D.J.; Latour, D.; Gachon, C.M.M.; Ogtrop, F.; Van Gleason, F.H.; Sime-ngando, T. Microbial players involved in the decline of filamentous and colonial cyanobacterial blooms with a focus on fungal parasitism. Environ. Microbiol. 2015, 17, 2573–2587. [Google Scholar] [CrossRef]
- Liu, Q.; Sun, B.; Huo, Y.; Liu, M.; Shi, J.; Jiang, T.; Zhang, Q.; Tang, C.; Bi, H.; He, P. Nutrient bioextraction and microalgae growth inhibition using submerged macrophyte Myriophyllum spicatum in a low salinity area of East China Sea. Mar. Pollut. Bull. 2018, 127, 67–72. [Google Scholar] [CrossRef]
- Montemezzani, V.; Duggan, I.C.; Hogg, I.D.; Craggs, R.J. Screening of potential zooplankton control technologies for wastewater treatment High Rate Algal Ponds. Algal Res. 2017, 22, 1–13. [Google Scholar] [CrossRef]
- Wichelen, J.; Van Vanormelingen, P.; Codd, G.A.; Vyverman, W. The common bloom-forming cyanobacterium Microcystis is prone to a wide array of microbial antagonists. Harmful Algae 2016, 55, 97–111. [Google Scholar] [CrossRef]
- Huisman, J.; Codd, G.A.; Paerl, H.W.; Ibelings, B.W.; Verspagen, J.M.H.; Visser, P.M. Cyanobacterial blooms. Nat. Rev. Microbiol. 2018, 16, 471–483. [Google Scholar] [CrossRef]
- Schwartz, N.; Dobretsov, S.; Rohde, S.; Schupp, P.J. Comparison of antifouling properties of native and invasive Sargassum (Fucales, Phaeophyceae) species. Eur. J. Phycol. 2017, 52, 116–131. [Google Scholar] [CrossRef]
- Chalabi, A.; Semroud, R.; Grimes, S. Plan d’action Stratégique Pour La Conservation de La Diversité Biologique en Région Méditerranéenne. 2015. Available online: http://www.abhatoo.net.ma/maalama-textuelle/developpement-economique-et-social/developpement-economique/planification/planification-de-l-environnement/plan-d-action-strategique-pour-la-conservation-de-la-diversite-biologique-en-region-mediterraneenne-rapport-national-maroc (accessed on 17 August 2020).
- Sun, Y.; Meng, K.; Su, Z.; Guo, G.; Pu, Y.; Wang, C. Isolation and purification of antialgal compounds from the red alga Gracilaria lemaneiformis for activity against common harmful red tide microalgae. Environ. Sci. Pollut. Res. 2017, 24, 4964–4972. [Google Scholar] [CrossRef] [PubMed]
- Barani, M.; Yousefzadi, M.; Moezi, M. Essential oils, new source of algicidal compounds. J. Appl. Phycol. 2015, 27, 267–273. [Google Scholar] [CrossRef]
- Najem, A.M.; Abed, I.J.; Al-haidari, A.M.D. Evaluation the activity of Rosemary (Rosmarinus officinalis L.) essential oil against some cyanobacteria. Iraqi J. Biotechnol. 2016, 15, 97–102. [Google Scholar]
- Najem, A.M.; Abed, I.J. Potential use of rosemary (Rosmarinus officinalis L.) essential oil as Anti- bacterial and anti-algal. J. Pharm. Biol. Sci. 2018. [Google Scholar] [CrossRef]
- Wang, H.; Liang, F.; Zhang, L. Composition and anti-cyanobacterial activity of essential oils from six different submerged macrophytes. Pol. J. Environ. Stud. 2015, 24, 333–338. [Google Scholar] [CrossRef]
- Zerrifi, E.A.S.; Kasrati, A.; Redouane, E.; Tazart, Z.; El khaloufi, F.; Abbad, A.; Oudra, B.; Campos, A.; Vasconcelos, V. Essential oils from Moroccan plants as promising ecofriendly tools to control toxic cyanobacteria blooms. Ind. Crops Prod. 2020, 143, 111922. [Google Scholar] [CrossRef]
- Zerrif, S.E.A.; El Ghazi, N.; Douma, M.; El Khalloufi, F.; Oudra, B. Potential uses of seaweed bioactive compounds forharmful microalgae blooms control: Algicidal effects and algal growth inhibition of Phormidium sp (freshwater toxic cyanobacteria). Smetox J. 2018, 1, 59–62. [Google Scholar]
- Zerrifi, S.E.A.; Tazart, Z.; El Khalloufi, F.; Oudra, B.; Campos, A.; Vasconcelos, V. Potential control of toxic cyanobacteria blooms with Moroccan seaweed extracts. Environ. Sci. Pollut. Res. 2019, 1–11. [Google Scholar] [CrossRef]
- Patra, J.K.; Lee, S.-W.; Kwon, Y.-S.; Park, J.G.; Baek, K.-H. Chemical characterization and antioxidant potential of volatile oil from an edible seaweed Porphyra tenera (Kjellman, 1897). Chem. Cent. J. 2017, 11, 34. [Google Scholar] [CrossRef]
- Patra, J.K.; Das, G.; Baek, K. Antibacterial mechanism of the action of Enteromorpha linza L. essential oil against Escherichia coli and Salmonella Typhimurium. Bot. Stud. 2015. [Google Scholar] [CrossRef]
- Patra, J.K.; Baek, K. Anti-listerial activity of four seaweed essential oils against Listeria monocytogenes. Jundishapur J. Microbiol. 2016, 9. [Google Scholar] [CrossRef] [PubMed]
- Patra, J.K.; Baek, K. Antibacterial activity and action mechanism of the essential oil from Enteromorpha linza L. against foodborne pathogenic bacteria. Molecules 2016, 21, 388. [Google Scholar] [CrossRef] [PubMed]
- Gaysinski, M.; Ortalo-Magné, A.P.; Thomas, O.; Culioli, G. Extraction, purification, and NMR analysis of terpenes from brown algae. In Natural Products from Marine Algae: Methods and Protocols; Humana Press: New York City, NY, USA, 2015; pp. 207–223. ISBN 9781493926848. [Google Scholar]
- Patra, J.K.; Lee, S.; Park, J.G.; Baek, K. Antioxidant and antibacterial properties of essential oil extracted from an edible seaweed Undaria pinnatifida. J. Food Biochem. 2017, 41, e12278. [Google Scholar] [CrossRef]
- Patra, J.K.; Das, G.; Baek, K. Chemical composition and antioxidant and antibacterial activities of an essential oil extracted from an edible seaweed, Laminaria japonica L. Molecules 2015, 20, 12093–12113. [Google Scholar] [CrossRef]
- Ozdemir, G.; Horzum, Z.; Sukatar, A.; Karabay-yavasoglu, N.U. Antimicrobial activities of volatile components and various extracts of Dictyopteris membranaceae and Cystoseira barbata from the coast of Izmir, Turkey. Pharm. Biol. 2006, 44, 183–188. [Google Scholar] [CrossRef]
- Kamenarska, Z.; Yalçin, F.N.; Ersöz, T.; Çaliş, I.; Stefanov, K.; Popov, S. Chemical composition of Cystoseira crinita Bory from the Eastern Mediterranean. Z. Nat. 2002, 57, 584–590. [Google Scholar] [CrossRef]
- Riad, N.; Zahi, M.R.; Trovato, E.; Bouzidi, N.; Daghbouche, Y.; Utczás, M.; Mondello, L.; El Hattab, M. Chemical screening and antibacterial activity of essential oil and volatile fraction of Dictyopteris polypodioides. Microchem. J. 2020, 152, 104415. [Google Scholar] [CrossRef]
- Gressler, V.; Colepicolo, P.; Pinto, E. Useful strategies for algal volatile analysis. Curr. Anal. Chem. 2009, 5, 271–292. [Google Scholar] [CrossRef]
- Salvador, N.; Garreta, A.G.; Lavelli, L.; Ribera, M.A. Antimicrobial activity of Iberian macroalgae. Sci. Mar. 2007, 71, 101–113. [Google Scholar] [CrossRef]
- Mishra, A.K. Sargassum, Gracilaria and Ulva exhibit positive antimicrobial activity against human pathogens. OALib 2018, 5, 1–11. [Google Scholar] [CrossRef]
- Begum, S.; Nyandoro, S.; Buriyo, A.; Makangara, J.; Munissi1, J.; Duffy, S.; Avery, V.; Erdelyi, M. Bioactivities of extracts, debromolaurinterol and fucosterol from macroalgae species. Tanzan. J. Sci. 2018, 44, 104–116. [Google Scholar]
- Kumaresan, M.; Vijai Anand, K.; Govindaraju, K.; Tamilselvan, S.; Ganesh Kumar, V. Seaweed Sargassum wightii mediated preparation of zirconia (ZrO2) nanoparticles and their antibacterial activity against gram positive and gram negative bacteria. Microb. Pathog. 2018, 124, 311–315. [Google Scholar] [CrossRef] [PubMed]
- Sujatha, R.; Siva, D.; Mohideen, P.N.A. Screening of phytochemical profile and antibacterial activity of various solvent extracts of marine algae Sargassum swartzii. World Sci. News 2019, 115, 27–40. [Google Scholar]
- Moorthi, P.V.; Balasubramanian, C. Antimicrobial properties of marine seaweed, Sargassum muticum against human pathogens. J. Coast. Life Med. 2015, 1–5. [Google Scholar] [CrossRef]
- Farid, Y.; Etahiri, S.; Assobhei, O. Activité antimicrobienne des algues marines de la lagune d’Oualidia (Maroc): Criblage et optimisation de la période de la récolte. Appl. Biosci. 2009, 24, 1543–1552. [Google Scholar]
- Chiheb, I.; Hassane, R.; Martinez-Lopez, J.; Dominguez Seglar, J.F.; Gomez Vidal, J.A.; Bouziane, H.; Mohamed, K. Screening of antibacterial activity in marine green and brown macroalgae from the coast of Morocco. Afr. J. Biotechnol. 2009, 8, 1258–1262. [Google Scholar] [CrossRef]
- Ainane, T.; Abourriche, A.; Kabbaj, M.; Elkouali, M.; Bennamara, A.; Charrouf, M.; Talbi, M.; Lemrani, M. Biological activities of extracts from seaweed Cystoseira tamariscifolia: Antibacterial activity, antileishmanial activity and cytotoxicity. J. Chem. Pharm. Res. 2014, 6, 607–611. [Google Scholar]
- Saleh, B.; Al-Hallab, L.; Al-Mariri, A. Seaweed extracts effectiveness against selected Gram-negative bacterial isolates. Biol. Sci. PJSIR 2019, 62, 101–110. [Google Scholar]
- Wang, H.; Liang, F.; Qiao, N.; Dong, J.; Zhang, L.; Guo, Y. Chemical composition of volatile oil from two emergent plants and their algae inhibition activity. Pol. J. Environ. Stud. 2014, 23, 2371–2374. [Google Scholar]
- Xian, Q.; Chen, H.; Zou, H.; Yin, D. Allelopathic activity of volatile substance from submerged macrophytes on Microcystin aeruginosa. Acta Ecol. Sin. 2006, 26, 3549–3554. [Google Scholar] [CrossRef]
- Harada, K.; Ozaki, K.; Tsuzuki, S. Blue color formation of cyanobacteria with β-cyclocitral. J. Chem. Ecol. 2009, 35, 1295–1301. [Google Scholar] [CrossRef] [PubMed]
- Huang, J.J.; Kolodnyy, N.H.; Redfeam, J.T.; Allen, M.M. The acid stress response of the cyanobacterium Synochocystis sp. strain PCC 6308. Arch. Microbiol. 2002, 177, 486–493. [Google Scholar] [CrossRef]
- Leu, E.; Krieger-liszkay, A.; Goussias, C.; Gross, E.M. Polyphenolic allelochemicals from the aquatic angiosperm. Society 2002, 130, 2011–2018. [Google Scholar] [CrossRef]
- Ni, L.; Acharya, K.; Hao, X.; Li, S. Isolation and identification of an anti-algal compound from Artemisia annua and mechanisms of inhibitory effect on algae. Chemosphere 2012, 88, 1051–1057. [Google Scholar] [CrossRef]
- Wu, L.; Qiu, Z.; Zhou, Y.; Du, Y.; Liu, C.; Ye, J.; Hu, X. Physiological effects of the herbicide glyphosate on the cyanobacterium Microcystis aeruginosa. Aquat. Toxicol. 2016, 178, 72–79. [Google Scholar] [CrossRef]
- Meng, P.; Pei, H.; Hu, W.; Liu, Z.; Li, X.; Xu, H. Allelopathic effects of Ailanthus altissima extracts on Microcystis aeruginosa growth, physiological changes and microcystins release. Chemosphere 2015, 141, 219–226. [Google Scholar] [CrossRef]
- Hua, Q.; Liu, Y.; Yan, Z.; Zeng, G.; Liu, S.; Wang, W. Allelopathic effect of the rice straw aqueous extract on the growth of Microcystis aeruginosa. Ecotoxicol. Environ. Saf. 2018, 148, 953–959. [Google Scholar] [CrossRef]
- Chai, T.; Zhu, H.D.; Yan, H.Z.; Zhao, D.; Liu, X.Y.; Fu, H.Y. Allelopathic effects of two organic acids on Microcystis aeruginosa. Earth Environ. Sci. 2018, 146. [Google Scholar] [CrossRef]
- Du, Y.; Ye, J.; Wu, L.; Yang, C.; Wang, L.; Hu, X. Physiological effects and toxin release in Microcystis aeruginosa and Microcystis viridis exposed to herbicide fenoxaprop-p-ethyl. Environ. Sci. Pollut. Res. 2017, 24, 7752–7763. [Google Scholar] [CrossRef]
- Bai, L.; Cao, C.; Wang, C.; Zhang, H.; Deng, J.; Jiang, H. Response of bloom-forming cyanobacterium Microcystis aeruginosa to 17Β-estradiol at different nitrogen levels. Chemosphere 2019, 219, 174–182. [Google Scholar] [CrossRef] [PubMed]
- Hou, X.; Huang, J.; Tang, J.; Wang, N.; Zhang, L.; Gu, L.; Sun, Y.; Yang, Z.; Huang, Y. Allelopathic inhibition of juglone (5-hydroxy-1,4-naphthoquinone) on the growth and physiological performance in Microcystis aeruginosa. J. Environ. Manag. 2019, 232, 382–386. [Google Scholar] [CrossRef] [PubMed]
- Wang, F.; Liu, D.; Qu, H.; Chen, L.; Zhou, Z.; Wang, P. A full evaluation for the enantiomeric impacts of lactofen and its metabolites on aquatic macrophyte Lemna minor. Water Res. 2016, 101, 55–63. [Google Scholar] [CrossRef] [PubMed]
- Zhang, Q.; Song, Q.; Wang, C.; Zhou, C.; Lu, C.; Zhao, M. Effects of glufosinate on the growth of and microcystin production by Microcystis aeruginosa at environmentally relevant concentrations. Sci. Total Environ. 2017, 575, 513–518. [Google Scholar] [CrossRef] [PubMed]
- Wang, J.; Liu, Q.; Feng, J.; Lv, J.; Xie, S. Effect of high-doses pyrogallol on oxidative damage, transcriptional responses and microcystins synthesis in Microcystis aeruginosa TY001 (Cyanobacteria). Ecotoxicol. Environ. Saf. 2016, 134, 273–279. [Google Scholar] [CrossRef] [PubMed]
- Xie, J.; Zhao, L.; Liu, K.; Liu, W. Enantiomeric environmental behavior, oxidative stress and toxin release of harmful cyanobacteria Microcystis aeruginosa in response to napropamide and acetochlor. Environ. Pollut. 2019, 246, 728–733. [Google Scholar] [CrossRef]
- Gayral, P. Les algues de la côte Atlantique marocaine. Bull. Société Des Sci. Nat. Phys. Maroc. 1958, 42, 1–34. [Google Scholar]
- Falcão, S.; Bacém, I.; Igrejas, G.; Rodrigues, P.J.; Vilas-Boas, M.; Amaral, J.S. Chemical composition and antimicrobial activity of hydrodistilled oil from Juniper berries. Ind. Crops Prod. 2018, 124, 878–884. [Google Scholar] [CrossRef]
- NCCLS. Performance Standards for Antimicrobial Disk Susceptibility Test, 6th ed.; NCCLS: Annapolis Junction, MD, USA, 1997. [Google Scholar]
- NCCLS. Methods for Dilution Antimicrobial Susceptibility Tests for Bacteria That Grow Aerobically, 4th ed.; NCCLS: Annapolis Junction, MD, USA, 1997. [Google Scholar]
- Sbiyyaa, B.; Loudiki, M.; Oudra, B. Capacité de stockage intracellulaire de l’azote et du phosphore chez Microcystis aeruginosa Kütz. t Synechocystis sp.: Cyanobactéries toxiques occasionnant des blooms dans la région de Marrakech (Maroc). Int. J. Limnol. Ann. Limnol. 1998, 34, 247–257. [Google Scholar] [CrossRef]
- Xu, H.; Paerl, H.W.; Qin, B.Q.; Zhu, G.W.; Gao, G. Nitrogen and phosphorus inputs control phytoplankton growth in eutrophic Lake Taihu, China. Limnol. Oceanogr. 2010, 55, 420–432. [Google Scholar] [CrossRef]
- Lichtenthaler, H.; Wellburn, A. Determinations of total carotenoids and Chlorophylls b of leaf extracts in different solvents. Biochem. Soc. Trans. 1983, 11, 591–592. [Google Scholar] [CrossRef]
- Li, J.; Liu, Y.; Zhang, P.; Zeng, G.; Cai, X.; Liu, S.; Yin, Y.; Hu, X.; Hu, X.; Tan, X. Growth inhibition and oxidative damage of Microcystis aeruginosa induced by crude extract of Sagittaria trifolia tubers. J. Environ. Sci. 2016, 43, 40–47. [Google Scholar] [CrossRef] [PubMed]
- Bradford, M.M. A rapid and sensitive method for the quantitation of microgram quantities of protein utilizing the principle of proteindye binding. Anal. Biochem. 1976, 72, 248–254. [Google Scholar] [CrossRef]
- Beauchamp, C.; Fridovich, I. Superoxide Dismutase: Improved assays and an assay applicable to acrylamide gels. Anal. Biochem. 1971, 44, 276–287. [Google Scholar] [CrossRef]
- Rao, M.V.; Paliyath, G.; Ormrod, D.P. Ultraviolet-B- and ozone-induced biochemical changes in antioxidant enzymes of Arabidopsis thaliana. Plant. Physiol. 1996, 110, 125–136. [Google Scholar] [CrossRef] [PubMed]

| Species | EO Total Content (%, v/w) |
|---|---|
| Ulva lactuca | 0.19 ± 0.08 |
| Sargassum muticum | 0.11 ± 0.02 |
| Cystoseira tamariscifolia | 0.06 ± 0.02 |
| Relative % c | |||||||
|---|---|---|---|---|---|---|---|
| Nº | Compound | RT (min) | LRI a | LRI b | Ct | Sm | Ul |
| 1 | (E)-2-Pentenal | 6.27 | 750 | 744 | - | - | 0.086 ± 0.002 |
| 2 | 4-Methyl-2-pentanol | 6.42 | 754 | 745 | - | - | 0.0063 ± 0.0002 |
| 3 | Toluene | 6.69 | 763 | 756 | - | - | 0.143 ± 0.004 |
| 4 | Hexanal or n-Caproylaldehyde | 7.92 | 800 | 801 | 0.196 ± 0.001 | 0.44 ± 0.02 | 0.23 ± 0.01 |
| 5 | Furfural | 9.24 | 828 | 828 | 0.19 ± 0.01 | 0.069 ± 0.002 | - |
| 6 | 4-Hexen-3-one | 9.41 | 832 | - | - | - | 0.075 ± 0.001 |
| 7 | 3-Hexen-2-one | 9.73 | 839 | 834 * | - | - | 0.046 ± 0.003 |
| 8 | (E)-2-Hexenal | 10.17 | 848 | 846 | 0.085 ± 0.003 | 0.35 ± 0.01 | 0.347 ± 0.003 |
| 9 | 2-Furanmethanol | 10.37 | 852 | 853 * | 0.57± 0.01 | - | - |
| 10 | 1-Hexanol | 11.11 | 868 | 863 | - | 0.063 ± 0.005 | 0.023 ± 0.001 |
| 11 | 4-Cyclopentene-1,3-dione | 11.67 | 880 | 880 * | 0.6 ± 0.01 | 0.02 ± 0 | - |
| 12 | 2-Heptanone | 12.05 | 888 | 889 | - | 0.029 ± 0.001 | 0.35 ± 0.01 |
| 13 | cis-4-Heptenal | 12.47 | 897 | 893 | - | 0.115 ± 0.005 | 0.28 ± 0.01 |
| 14 | n-Heptanal | 12.57 | 900 | 901 | 0.29 ± 0.01 | 0.136 ± 0.003 | 0.293 ± 0.002 |
| 15 | Acetylfuran | 12.99 | 908 | 909 | 0.2 ± 0.005 | 0.176 ± 0.002 | - |
| 16 | 2-Cyclohexen-1-one | 13.98 | 927 | 927 * | 0.102 ± 0.002 | - | - |
| 17 | α-Pinene | 14.20 | 931 | 932 | - | 0.0151 ± 0.0001 | - |
| 18 | Cyclohexen-2-one | 14.22 | 931 | - | - | - | 0.07 ± 0.001 |
| 19 | Hept-3-en-2-one | 14.37 | 934 | 927 | - | 0.038 ± 0.004 | 0.052 ± 0.003 |
| 20 | Benzaldehyde | 15.00 | 956 | 952 | 0.31 ± 0.01 | 0.38 ± 0.01 | 0.569 ± 0.004 |
| 21 | 5-Methyl-furfural | 15.71 | 960 | 957 | 0.737 ± 0.001 | 0.988 ± 0.02 | 3.39 ± 0.05 |
| 22 | 3,5,5-Trimethyl-2-hexene | 16.47 | 975 | - | - | - | 0.192 ± 0.004 |
| 23 | 1-Octen-3-ol | 16.63 | 978 | 974 | 0.103 ± 0.004 | 0.2036 ± 0.0001 | - |
| 24 | 2-methyl-3-Octanone | 16.91 | 983 | 985 * | - | 0.318 ± 0.004 | - |
| 25 | 6-Methyl-5-heptene-2-one | 16.99 | 985 | 986 * | - | 0.056 ± 0.004 | - |
| 26 | 3-Methyl-3-cyclohexen-1-one | 17.00 | 985 | - | - | - | 0.69 ± 0.02 |
| 27 | Octanal | 17.81 | 1000 | 998 | 0.206 ± 0.003 | - | - |
| 28 | Pyrrole-2-carboxaldehyde | 18.12 | 1006 | 1008 * | - | 0.17 ± 0.01 | - |
| 29 | (E,E)-2,4-Heptadienal | 18.16 | 1007 | 1005 | 0.29 ± 0.01 | 0.09 ± 0.01 | 0.466 ± 0.003 |
| 30 | 4-Oxohex-2-enal | 19.49 | 1033 | - | 1.43 ± 0.03 | - | |
| 31 | 2,2,6-Trimethyl-Cyclohexanone | 19.56 | 1034 | 1036 * | - | - | 0.83 ± 0.04 |
| 32 | Benzeneacetaldehyde | 19.93 | 1041 | 1036 | 1.9 ± 0.03 | 4.62 ± 0.04 | 0.822 ± 0.003 |
| 33 | γ-Hexalactone | 20.39 | 1050 | 1047 | - | 0.42 ± 0.01 | 1.14 ± 0.01 |
| 34 | 2,4,4-Trimethyl-2-cyclohexen-1-ol | 20.42 | 1051 | - | 0.65 ± 0.01 | - | - |
| 35 | (E)-2-Octenal | 20.66 | 1055 | 1049 | 0.104 ± 0.001 | 0.149 ± 0.01 | - |
| 36 | (R)-3,5,5-Trimethylcyclohex-3-en-1-ol | 21.09 | 1063 | - | - | - | 0.187 ± 0.003 |
| 37 | 3-Methyl-benzaldehyde | 21.27 | 1067 | 1064 | - | - | 0.26 ± 0.01 |
| 38 | 1-Octanol | 21.39 | 1069 | 1063 | 0.23 ± 0.004 | - | - |
| 39 | 3,5-Octadien-2-one | 22.60 | 1093 | 1093 | - | - | 0.63 ± 0.02 |
| 40 | Phenylethyl Alcohol | 23.49 | 1110 | 1115 * | - | 1.14 ± 0.02 | - |
| 41 | Isophorone | 23.95 | 1120 | 1118 | - | - | 0.51 ± 0.01 |
| 42 | 4-Oxoisophorone | 25.01 | 1141 | 1142 * | 0.29 ± 0.01 | 0.813 ± 0.005 | 0.341 ± 0.01 |
| 43 | Isomenthone | 25.56 | 1152 | 1162 * | - | 0.485 ± 0.003 | - |
| 44 | 2,6-Nonadienal, (E,Z) | 25.61 | 1153 | 1150 | - | - | 0.35 ± 0.005 |
| 45 | (E)-2-Nonenal | 25.81 | 1157 | 1157 | 0.279 ± 0.005 | - | - |
| 46 | 1-Phenyl-1-propanone | 26.19 | 1165 | - | - | - | 0.49 ± 0.01 |
| 47 | 2,2,6-Trimethyl-1,4-cyclohexanedione | 26.33 | 1167 | - | - | - | 0.274 ± 0.003 |
| 48 | 2,4-Dimethyl-benzaldehyde | 26.67 | 1175 | 1175 * | - | - | 0.305 ± 0.01 |
| 49 | 1-(4-Methylphenyl)-ethanone | 27.02 | 1181 | 1182 | 0.43 ± 0.01 | - | - |
| 50 | p-Methylacetophenone | 27.15 | 1184 | 1179 | - | - | 0.54 ± 0.03 |
| 51 | Safranal | 27.82 | 1198 | 1197 | 0.97 ± 0.01 | - | 1.8 ± 0.1 |
| 52 | β-Cyclocitral | 28.84 | 1219 | 1219 | - | 0.479 ± 0.001 | 0.614 ± 0.002 |
| 53 | Ethylmethylmaleimide | 29.67 | 1237 | 1234 | 1.562 ± 0.03 | 3.69 ± 0.03 | 0.59 ± 0.01 |
| 54 | Pulegone | 29.73 | 1238 | 1233 | - | 0.375 ± 0.003 | - |
| 55 | 2,6,6-Trimethyl-1-Cyclohexene-1-acetaldehyde | 30.70 | 1259 | 1253 * | - | - | 0.53 ± 0.01 |
| 56 | 2,3,6-Trimethyl-7-octen-3-ol | 31.53 | 1277 | - | - | 1.846 ± 0.01 | - |
| 57 | Indole | 32.47 | 1297 | 1290 | - | - | 1.026 ± 0.003 |
| 58 | Carvacrol | 32.69 | 1302 | 1298 | 0.98 ± 0.02 | - | - |
| 59 | γ-Amylbutyrolactone | 35.29 | 1361 | 1362 * | - | 1.03 ± 0.02 | - |
| 60 | Capric acid | 35.97 | 1376 | - | 1.15 ± 0.02 | - | - |
| 61 | Fumaric acid, ethyl 2-methylallyl ester | 36.27 | 1383 | - | - | 1.45 ± 0.03 | - |
| 62 | β-Caryophyllene | 37.91 | 1421 | 1417 | - | 0.02 ± 0.004 | - |
| 63 | α-Ionone | 38.22 | 1428 | 1428 | 3.23 ± 0.02 | 3.07 ± 0.03 | 1.1 ± 0.01 |
| 64 | Nerylacetone | 39.27 | 1454 | 1434 | - | - | 0.26 ± 0.01 |
| 65 | β-Ionone | 40.88 | 1492 | 1488 | 1.3 ± 0.03 | - | 7.6 ± 0.2 |
| 66 | Dihydroactinidiolide | 42.49 | 1536 | 1538 * | 6.577 ± 0.004 | 6.971 ± 0.003 | 7.8 ± 0.2 |
| 67 | Lauric acid | 43.66 | 1562 | 1565 | 2.9 ± 0.1 | 0.49 ± 0.01 | 1.2 ± 0.1 |
| 68 | Fumaric acid, ethyl 2-Methylallyl ester | 44.46 | 1583 | - | - | - | 3.0 ± 0.1 |
| 69 | Tridecanoic acid | 47.61 | 1666 | 1662 | - | - | 0.1979 ± 0.0003 |
| 70 | 3-Keto-β-ionone | 47.77 | 1670 | 1661 * | - | 1.29 ± 0.02 | - |
| 71 | 4-(4-hydroxy-2,2,6-trimethyl-7-oxabicyclo[4.1.0]hept-1-yl)-3-Buten-2-one | 48.40 | 1687 | 1690 | - | 1.2 ± 0.1 | - |
| 72 | Heptadecane | 48.77 | 1697 | 1700 | 4.14 ± 0.04 | - | - |
| 73 | Pentadecanal | 49.37 | 1711 | 1713 | - | - | 0.27 ± 0.01 |
| 74 | Myristic acid | 50.61 | 1769 | 1765 * | 2.2 ± 0.1 | 2.16 ± 0.01 | 1.855 ± 0.001 |
| 75 | Pentadecanoic acid | 51.81 | 1820 | 1869 | - | - | 0.121 ± 0.004 |
| 76 | Hexahydrofarnesyl acetone | 52.07 | 1847 | - | 5.1 ± 0.1 | - | - |
| 77 | 2-Pentadecanone, 6,10,14-trimethyl | 52.11 | 1843 | 1847 | - | - | 0.23 ± 0.01 |
| 78 | Methyl 4,7,10,13-hexadecatetraenoate | 52.68 | 1885 | - | - | - | 0.15 ± 0.01 |
| 79 | Eicosane | 52.80 | 1895 | - | 0.22 ± 0.02 | - | - |
| 80 | Palmitoleic acid | 53.41 | 1948 | 1953* | - | 7.8 ± 0.1 | - |
| 81 | Eicosapentaenoic acid | 53.57 | 1962 | - | - | - | 8.0 ± 0.2 |
| 82 | Palmitic acid | 53.64 | 1968 | 1959 | 7.7 ± 0.1 | 0.73 ± 0.01 | 2.887 ± 0.02 |
| 83 | Phytol | 55.00 | 2113 | 2111 * | 4.1 ± 0.1 | 0.38 ± 0.03 | 0.23 ± 0.01 |
| 84 | Linolenic acid | 55.36 | 2159 | 2134 * | - | - | 1.2 ± 0.1 |
| 85 | Eicosanal | 55.83 | 2223 | 2224 | 0.7 ± 0.1 | - | - |
| 86 | 1-Hexacosanol | 56.25 | 2283 | 2906 | 1.39 ± 0.05 | - | - |
| 87 | Henicosanal | 56.52 | 2325 | 2329 | 0.89 ± 0.04 | - | - |
| 88 | Docosanal | 57.15 | 2427 | 2434 | 1.38 ± 0.04 | - | - |
| 89 | 1-Docosanol | 57.51 | 2488 | 2470 | 2.423 ± 0.004 | - | - |
| 90 | Tricosanal | 57.75 | 2529 | 2534 | 2.8 ± 0.1 | - | - |
| 91 | Bis (2-ethylhexyl) phthalate | 57.95 | 2562 | 2550 * | - | - | 0.5 ± 0.1 |
| Total identified (%) | 59.6 ± 0.1 | 45.7 ± 0.1 | 55 ± 1 | ||||
| Not identified (%) | 40.4 ± 0.1 | 54.3 ± 0.1 | 45 ± 1 |
| Treatments | Inhibition Zone (mm) | MIC (μg mL−1) | MBC (μg mL−1) |
|---|---|---|---|
| C. tamariscifolia | 46.3 ± 0.6 *** | 7.81 | 15.62 |
| S. muticum | 32.3 ± 0.6 *** | 62.5 | 125 |
| U. lactuca | n.a | n.a | n.a |
| CuSO4 | 45.3 ± 0.6 *** | 3.12 | 3.12 |
| DMSO | n.a | n.a | n.a |
| Treatments | Inhibition Rate (%) | |||||
|---|---|---|---|---|---|---|
| Time (Days) | ||||||
| 1 | 2 | 3 | 4 | 5 | 6 | |
| MIC | 68.0 ± 0.4 *** | 87.6 ± 0.4 *** | 90.2 ± 0.5 *** | 95.4 ± 0.1 *** | 96.16 ± 0.08 *** | 97.85 ± 0.05 *** |
| MBC | 74 ± 1 *** | 89.9 ± 0.2 *** | 94.4 ± 0.3 *** | 97.8 ± 0.1 *** | 98.81 ± 0.07 *** | 99.24 ± 0.07 *** |
| CuSO4 | 71 ± 2 *** | 88.9 ± 0.2 *** | 94.12 ± 0.07 *** | 97.54 ± 0.05 *** | 98.5 ± 0.02 *** | 98.87 ± 0.01 *** |
| DMSO | −0.3 ± 0.5 | −0.08 ± 1.67 | −0.15 ± 0.39 | −1.0 ± 0.6 | −1 ± 2 | −1.1 ± 0.9 |
| Species | Species Code | Harvesting Place | Date of Harvesting | Latitude/Longitude |
|---|---|---|---|---|
| C. tamariscifolia | Ct | Souiria Laqdima | February 2019 | N 32°03′04.6″/W 9°20′30.2″ |
| S. muticum | Sm | El jadida | April 2019 | N 3°15′45.9″/W 8°30′03.4″ |
| U. lactuca | Ul | El jadida | March 2019 | N 3°15′45.9″/W 8°30′03.4″ |
© 2020 by the authors. Licensee MDPI, Basel, Switzerland. This article is an open access article distributed under the terms and conditions of the Creative Commons Attribution (CC BY) license (http://creativecommons.org/licenses/by/4.0/).
Share and Cite
El Amrani Zerrifi, S.; El Khalloufi, F.; Mugani, R.; El Mahdi, R.; Kasrati, A.; Soulaimani, B.; Barros, L.; Ferreira, I.C.F.R.; Amaral, J.S.; Finimundy, T.C.; et al. Seaweed Essential Oils as a New Source of Bioactive Compounds for Cyanobacteria Growth Control: Innovative Ecological Biocontrol Approach. Toxins 2020, 12, 527. https://doi.org/10.3390/toxins12080527
El Amrani Zerrifi S, El Khalloufi F, Mugani R, El Mahdi R, Kasrati A, Soulaimani B, Barros L, Ferreira ICFR, Amaral JS, Finimundy TC, et al. Seaweed Essential Oils as a New Source of Bioactive Compounds for Cyanobacteria Growth Control: Innovative Ecological Biocontrol Approach. Toxins. 2020; 12(8):527. https://doi.org/10.3390/toxins12080527
Chicago/Turabian StyleEl Amrani Zerrifi, Soukaina, Fatima El Khalloufi, Richard Mugani, Redouane El Mahdi, Ayoub Kasrati, Bouchra Soulaimani, Lillian Barros, Isabel C. F. R. Ferreira, Joana S. Amaral, Tiane Cristine Finimundy, and et al. 2020. "Seaweed Essential Oils as a New Source of Bioactive Compounds for Cyanobacteria Growth Control: Innovative Ecological Biocontrol Approach" Toxins 12, no. 8: 527. https://doi.org/10.3390/toxins12080527
APA StyleEl Amrani Zerrifi, S., El Khalloufi, F., Mugani, R., El Mahdi, R., Kasrati, A., Soulaimani, B., Barros, L., Ferreira, I. C. F. R., Amaral, J. S., Finimundy, T. C., Abbad, A., Oudra, B., Campos, A., & Vasconcelos, V. (2020). Seaweed Essential Oils as a New Source of Bioactive Compounds for Cyanobacteria Growth Control: Innovative Ecological Biocontrol Approach. Toxins, 12(8), 527. https://doi.org/10.3390/toxins12080527

